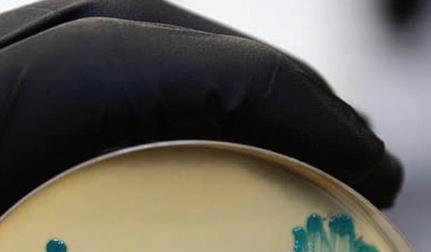
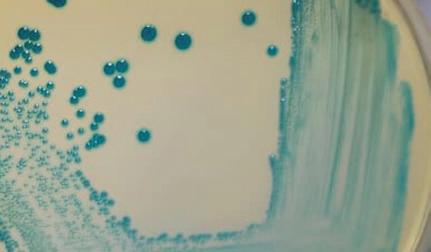
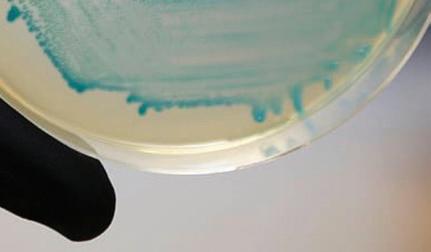

De NVWA houdt toezicht op - onder andere - de productie van veilig voedsel. Recente uitbraken en veranderingen in opsporingstechnieken vormen de aanleiding voor meer aandacht voor het ontwerp en de schoonmaak van machines. We praten erover met NVWA-inspecteurs Coen van der Weijden en Coen Graven.

Schoonmaken is een essentieel onderdeel van de algemene beheersmaatregelen binnen het HACCPplan. Toch gaat het af en toe mis. Een belangrijk - en vaak ondergeschoven - oorzaak is: verkeerd ontwerp, gecombineerd met een gebrek aan een serieuze validatie.
OSV netwerk 6 Vervuilingsproblematiek bij plantbased 20
Column Pieter Vos 23 Reportage bij Zuneha 28 Kleding- en krattenwassen 30 Voedselveilig smeren 37 Hygiënische vloeren en wanden 40
Column Marlous van Drunen 43

De huidige chemische en thermische processen die worden gebruikt om de hygiëne en veiligheid van producten te borgen, kennen nadelen. Koud plasma kan een mild alternatief zijn bij de bestrijding van micro-organismen, microbiële sporen en virussen.
Als je jouw klanten al 20 jaar belooft dat je de lekkerste broodjes smeert, dan heb je groot vertrouwen in de veiligheid en de hygiëne van het productieproces. Toch is er áltijd ruimte voor verbetering, vindt Walther de Haan, operational manager van Qizini in Alphen aan den Rijn.

Vakblad voor ondernemers en managers van foodproducerende bedrijven: VOEDINGSINDUSTRIE. Voedingsindustrie verschijnt acht maal per jaar in print. Het vakblad informeert ondernemers en managers van foodproducerende bedrijven met trends & ontwikkelingen, duurzaam ondernemen, innovaties, verpakken, hygiëne en voedselveiligheid, processing, procestechnologie en wetenschap. Meer info: www.vakbladvoedingsindustrie.nl Oplage: 3500. Vakblad VOEDINGSINDUSTRIE is een officieel orgaan van de Ondernemers Sociëteit Voedingsindustrie (OSV). Voorpaginafoto: ©Eco2Clean Aan deze uitgave werkten mee: Wouter Bruggraaf, Esther vd Lelie, Masja Nierop Groot, Wilfred Hoeben en Marco de Peuter, Naomi Heidinga Vormgeving: Roy Kempers Drukwerk: Drukwerkmax, Duiven. Vakblad VOEDINGSINDUSTRIE is een uitgave van b2b Communications BV. Hoofdredactie: Judith Witte. Uitgever: Saskia Stender. Traffic: Kiki Stender. Sales: sales@b2bcommunications.nl. Redactie en administratie: b2b Communications BV, Arnhemsestraatweg 19, Postbus 50, 6880 AB Velp. KvK 59203455. Telefoon +31(0) 26 3700027, info@b2bcommunications.nl, www.b2bcommunications.nl. Abonnementen: Voor opgave abonnement +31(0) 26 3700027. info@b2bcommunications.nl. Prijs per jaar € 80,00 (excl. btw); per los nummer € 15,-. Opzeggen van het abonnement kan alleen schriftelijk en uiterlijk twee maanden voor de eerstvolgende betaaldatum. Abonnementsgeld dient vooruit te worden betaald t.n.v. b2b Communications BV op NL52 RABO 0142 6810 75. Leveringsvoorwaarden: Op alle aanbiedingen, offertes en overeenkomsten van b2b Communications BV zijn de voorwaarden van toepassing, terug te lezen op www.b2bcommunications.nl. Copyright 2022: b2b Communications BV. Auteursrecht: ‘Alle rechten voorbehouden. Niets uit deze uitgave mag worden verveelvoudigd, opgeslagen in een geautomatiseerd gegevensbestand of openbaar gemaakt, in enige vorm of op enige wijze, hetzij elektronisch, mechanisch of door fotokopieën, opname of enige andere manier, zonder voorafgaande schriftelijke toestemming van de uitgever. Uitgever en redacteuren verklaren dat deze uitgave op zorgvuldige wijze en naar beste weten is samengesteld, evenwel kunnen zij op geen enkele wijze instaan voor de juistheid of volledigheid van de informatie; zij aanvaarden dan ook geen enkele aansprakelijkheid voor schade, van welke aard ook, die het gevolg is van handelingen en/of beslissingen die gebaseerd zijn op bedoelde informatie ISSN: 2213-5758.

Elk bedrijf een uniek schoonmaakplan... vanzelfsprekend. Aanpassingsvermogen... cruciaal.


De rol van de schoonmaker is veranderd: van generalist naar specialist, en van louter uitvoerder naar uitvoerder én adviseur met verstand van zaken

Voets, commercieel directeur












































































Aviko – onderdeel van Royal Cosun – opende onlangs een nieuwe fabriek voor diepvriesfrites en aardappelproducten in het Belgische West-Vlaanderen. De nieuwe fritesfabriek in Poperinge behoort tot de modernste van Europa dankzij de focus op energie-efficiëntie, duurzaamheid en op digitalisering waarmee productie-efficiëntie, kwaliteit en voedselveiligheid stevig zijn geborgd. Het vriesmagazijn is volledig geautomatiseerd en gerobotiseerd. De fabriek is voorzien van een warmtekrachtcentrale en op het dak van het vrieshuis liggen ruim 2.500 zonnepanelen. Restmaterialen zoals aardappelschillen worden hergebruikt voor o.a. diervoeders. Ook het aardappelzetmeel in het waswater wordt teruggewonnen en gebruikt voor de productie van behanglijmen en papier. “We blijven naar nieuwe wegen zoeken om bijproducten in dit proces verder te verwaarden, ook voor de voedingssector”, zegt Cor Koole, projectmanager van de site in Poperinge.

Voedselveiligheid blijft voor ons allemaal van groot belang. Nutrilab stelt zich op als loyale partner in het borgen van en controleren van voedselveiligheid. Wij blijven ook in deze tijd alle faciliteiten bieden die u van ons gewend bent. Wij denken van harte met u mee en weten bijvoorbeeld hoe belangrijk het is om preventieve maatregelen te nemen. Onze relaties moeten voortdurend op ons kunnen vertrouwen, ook in deze turbulente tijd. Onze passie voor voedselveiligheid maakt ons tot een betrokken en betrouwbare partner die de klant altijd centraal zet en zeer snel kan schakelen. Vragen? Neem contact met ons op, de gegevens staan op onze website.
www.nutrilab.nl


Innovatie zit in het DNA van Regio Foodvalley. Met slimme ideeën, onverwachte samenwerkingen en een gezonde dosis pragmatisme wordt er gewerkt aan de toekomst. De Innovatieprijs Regio Foodvalley zet de mooiste innovaties én de ondernemers die ze ontwikkelden in de schijnwerpers. No Palm Ingrediënts uit Ede won dit jaar de Innovatieprijs Regio Foodvalley. Het bedrijf ontwikkelt duurzame palmolievervangers door reststromen uit de agrifoodsector te fermenteren met oliehoudende gisten. Het proces is
te vergelijken met het brouwen van bier, maar dan met oliën en vetten. De publieksprijs ging naar XINTC uit Kootwijkerbroek. www.regiofoodvalley.nl






 door Judith Witte | foto’s ©Herbert Wiggerman
door Judith Witte | foto’s ©Herbert Wiggerman
‘Inspecteurs zullen tijdens de inspectie meer aandacht hebben voor de hygiëne, reiniging en desinfectie’Coen van der Weijden (l) en Coen Graven
De Nederlandse Voedsel en Waren Autoriteit (NVWA) houdt toezicht op - onder andere - de productie van veilig voedsel. Recente uitbraken en grote veranderingen in opsporingstechnieken vormen de aanleiding voor meer aandacht voor het ontwerp en de schoonmaak van machines. Wat betekent dat in de praktijk? We praten erover met twee NVWA-inspecteurs.
Het is een zonnige vrijdag in oktober. In een lichte vergaderruimte in het hoofdkantoor van de NVWA in Utrecht zijn twee NVWA-inspec teurs aangeschoven voor het interview: Coen van der Weijden, Coördinerend Specialistisch Inspecteur/ Microbiologie, en Coen Graven, Coördinerend Specialistisch Inspecteur / Toxicoloog. Het is zeker niet voor het eerst dat deze twee Coenen bij elkaar zitten; ook al zijn zij verantwoordelijk voor twee heel verschil lende domeinen. Hun samenwerking, en trou wens ook die met andere inspecteurs van weer heel ándere domeinen, is tekenend voor de
nieuwe koers die de NVWA is ingeslagen. Daar over straks meer. We beginnen bij het begin; de voedselveiligheid.
Waar ligt het grootste gevaar met betrekking tot de voedselveiligheid?
Van der Weijden: “Het beheersen van de microbiologische veiligheid staat met stip op één. Veel is daarom gericht op hygiënisch produceren: op reinigen, desinfecteren, han den wassen, et cetera. Over het algemeen gaat het heel goed, maar hygiëne blijft een continu aandachtspunt.”
“Ook chemische veiligheid is zeer relevant en belangrijk,” vult Graven aan. “Effecten van chemische stoffen zijn vaak niet zo zichtbaar, maar kunnen op langere termijn wel risicovol zijn.”
Binnen welk wettelijk kader houdt de Autori teit daar toezicht op?
Van der Weijden: “Levensmiddelenbedrijven zijn primair verantwoordelijk voor de voedsel veiligheid en het toepassen van relevante ver ordeningen, maar de bevoegde autoriteit kan een deel van de verantwoordelijkheid invullen; >>
denk aan risicocommunicatie. De NVWA toetst onder andere aan de General Food Law, ofwel de Algemene Levensmiddelen Verordening (ALV). Dit is in de basis doelgerichte wetgeving: voedsel dat op de markt gebracht wordt, moet veilig zijn. In afgeleide wetgeving staan de hygiëne-eisen en procedures vermeld waar aan producenten van levensmiddelen moeten voldoen. Dat is voor een aantal onderwerpen heel expliciet ingevuld, met name wettelijke criteria zoals de afwezigheid van Salmonella in meetbare porties van 25 gram product. Op deze ‘gesloten normen’ kunnen we inspecteren. Maar er zijn ook onderwerpen die minder expliciet zijn omschreven. Daarvoor zijn zogenaamde ‘open normen’ geformuleerd. Die geven een levensmiddelenfabrikant een hoge mate van flexibiliteit, maar het levert ook discussie op. Want waar ligt de grens tussen veilig en onveilig voedsel precies? En wanneer is een apparaat ‘schoon’ of ‘afdoende’ onder houden? Gesloten normen hebben vooral onze aandacht: die zijn meetbaar. Langzaamaan komt er ook meer aandacht voor de meer sub jectieve onderwerpen.”
Graven: “Bij voedselcontactmaterialen zijn de limieten heel duidelijk. Dit zijn ‘gesloten nor men’ waar een voedselcontactmateriaal aan moet voldoen. Echter hoe je dat analyseert kan soms discussies opleveren. De biocidenwetge ving bijvoorbeeld is kristalhelder, je moet wer ken met toegelaten middelen. Deze middelen zijn getest op werkzaamheid met harde eisen voor de reductie van kiemgetallen.”
Klopt het dat de wetgever jullie geen toetsend kader geeft rondom het ontwerp, schoonmaak en onderhoud van machines?
Van der Weijden: “Dat klopt, deels. Een ma chine móet voldoen aan de machinerichtlijn en een CE-markering hebben, maar dat volgt niet uit de voedselveiligheidswetgeving waar de NVWA op toeziet. Vanuit voedselveiligheids wetgeving wordt niet concreet benoemd wát er in de praktijk moet gebeuren om aan de
open normen te voldoen. Een werkgroep zoals EHEDG is met de onduidelijkheid rondom hygi enisch ontwerpen aan de slag gegaan. Wat zij adviseren zijn echter geen wettelijke normen.
Ik verwacht ook niet dat de richtlijn op korte termijn geïmplementeerd gaat worden in de wet, er lopen tenminste geen Europese trajec ten in die richting. En we moeten Nederlandse ondernemers geen strengere normen gaan opleggen dan in de rest van Europa. Zolang de levensmiddelenproducent een goedgekeurde relevante hygiënecode of eigen HACCP-plan heeft, deze in de praktijk toepast én zich houdt aan de eisen rondom voedselcontactmateria len, kunnen we op de EHEDG-richtlijnen niet handhaven.”
Maar er is wel wat in beweging gezet… Van der Weijden: “Ja, vanuit recente uitbraken hebben we geconcludeerd dat ons toezicht op het gebied van machines en schoonmaak versterkt kan worden. Die uitbraken hebben
Coen van der Weijden: ‘We mogen geen advies geven, maar kunnen wel laten zien wát er fout is’
we kunnen opsporen dankzij een vrij nieuwe techniek; ‘whole genome sequencing’, kortweg WGS. We kunnen hiermee het dna van bijvoor beeld een Listeriabacterie vaststellen. Met de methode kunnen we sneller een koppeling maken tussen de ziektegevallen die het RIVM signaleert en bronnen in de voedselketen, ofwel de monitoringsmonsters die door Wageningen Food Safety Research worden onderzocht. Deze techniek is een echte game changer. Listeria is moeilijk op te sporen. Af gelopen jaren is het ons dankzij WGS eindelijk gelukt om de bron van verschillende uitbraken te vinden. We moeten wel heel zorgvuldig met deze werkwijze omgaan. Zie het als een fo rensisch onderzoek bij een misdaad. Je moet eerst voldoende bewijs verzamelen en dat kost tijd. We willen een bedrijf niet onterecht ingrij pende maatregelen opleggen. Er is meestal ook geen schuldvraag; in de meeste gevallen doet een bedrijf alles naar eer en geweten, maar gaat het soms toch mis.”

Listeria-uitbraken werden tot 2017 sporadisch gemeld. In 2017 werd WGS in de landelijke surveillance geïntroduceerd ter vervanging van pulse field gel electroforese (PFGE). Met behulp van de gezamenlijke RIVM/WFSR-database worden sinds 2019 geregeld uitbraken gedetecteerd die gelinkt kunnen worden aan monitorings-isolaten uit levensmiddelenbedrijven. Daarna worden acties met de betreffende bedrijven genomen om verdere besmetting tegen te gaan. (Bron: Registratie voedselgerelateerde uitbraken in Nederland, 2021 RIVM-rapport 2022-0096I.H.M. Friesema et al.)
Hoever gaat de bronopsporing eigenlijk; tot en met de brandhaard ín de foodfabriek?
Van der Weijden: “We hebben helaas niet de luxe, tijd en geld om zó uitgebreid onderzoek te doen. Als we weten uit welke fabriek en welke productielijn(en) de besmetting komt, wordt de productie op die lijnen zo snel mogelijk stil gelegd om erger te voorkomen. Het is aan de ondernemer om zijn fabriek schoon te krijgen. Voor de inspecteur telt het feit dát de levens middelenproducent het beheerst. Wij vinden de primaire bron dus meestal niet.”

Komen die ook niet aan het licht tijdens de inspecties van de NVWA?
Van der Weijden: “De inspecteurs van de NVWA controleren gewoonlijk op reguliere
werktijden. Dat is het meest effectief, want dan zien ze hoe er gewerkt wordt als de lijnen operabel zijn. Het nadeel is wel dat er hierdoor een blinde vlek ontstaat. De inspecteur kan op dat moment namelijk niet ín de machi nes kijken en ziet niet hóe de schoonmaak wordt uitgevoerd, want dat gebeurt meestal ’s nachts.”
Graven: “Zeker bij het gebruik van biociden voor voedselverwerking zouden we er het liefst naast staan. Wordt het juiste middel gebruikt en wordt het middel juist gebruikt, zoals in de wet beschreven staat? Als het mis gaat, zit’ m dat vaak in het naspoelen. Dat moet gecon troleerd worden, daar zijn protocollen voor; er mogen aan het eind van de schoonmaak geen residuen meer aanwezig zijn. We kunnen na tuurlijk wel de validatierapporten beoordelen.”
Van der Weijden: “Wat we mede dankzij WGS ontdekten, is dat bedrijven vaak zelf niet door hebben dát - en waar precies in de fabriekhet fout gaat. Ook inspecteurs zagen bij de inspecties geen tekortkomingen. Toch bleek in een aantal gevallen de schoonmaak niet goed genoeg, waardoor er grote (Listeria)problemen konden ontstaan. Mede naar aanleiding van die uitbraken zijn we gestart met een nieuwe training voor onze inspecteurs, gericht op het herkennen van schoonmaakissues. Voor foodproducenten betekent dit dat inspecteurs tijdens de inspectie meer aandacht zullen hebben voor de hygiëne, reiniging en desinfec tie. Zij kunnen hierover specifieke vragen ver ‘Hoe wordt schoonmaak uitgevoerd? Is de schoonmaak gevalideerd? Worden mid delen gerouleerd om resistentie te voorkomen? Is het middel wel bedoeld voor voedselcontact materialen?’.”
Tegelijkertijd met de opkomst van WGS is er een trend gaande naar meer moleculaire diag nostiek in medische laboratoria. Wat betekent dat voor de bronopsporing?
Van der Weijden: “Dat vormt helaas een be dreiging voor het uitvoeren van een adequate >>
landelijke surveillance voor uitbraakdetectie, want daarmee komt de bacterie niet levend in handen, en verkrijgt het RIVM dus geen isolaten voor de benodigde WGS-analyse. We hopen niet dat dit doorzet. Diagnostische labs gebruiken de moleculaire diagnostiek overigens vooral voor het detecteren van STEC (Shigatoxineproducerende E.coli. red.).
Hopelijk gaan we dit niet terug zien bij Listeria of Salmonella.”
Wat is een belangrijk aandachtspunt met betrekking tot voedselcontactmaterialen en de machines waarmee voedsel wordt gepro duceerd?
Graven: “Producenten moeten zich realiseren dat wetgeving in de loop der tijd verandert. Vanaf 1 januari 2023 geldt er bijvoorbeeld een verbod op het gebruik van minerale oliën op verpakkingen en drukwerk dat onder het pu bliek wordt verspreid. Eenzelfde scenario komt er voor PFAS-sen. We weten niet op welke termijn dit gaat gebeuren, maar dát er een alomvattende restrictie komt, staat vast.”
Wat betekent dat concreet voor een onderne mer?
Graven: “Een machine die je twintig jaar ge leden kocht, voldoet daardoor misschien niet meer aan de recente wetgeving. Het is daarom essentieel om altijd up-to-date te zijn en con tact te houden met je leveranciers. Je móet weten welke materialen in jouw machines zijn verwerkt en of die nog zijn toegestaan. In de Kaderverordening voedselcontactmaterialen EG 1935/2004 staan regels over de traceer baarheid van materialen die in direct contact komen met voedsel. Producenten zijn wettelijk verplicht om in een systeem bij te houden waar hun grondstoffen of producten vandaan komen en aan wie dit geleverd is. Zo is bij een eventuele terugroepactie de traceerbaarheid gegarandeerd. Dat geldt óók voor alle onder delen en materialen die in de machines zijn verwerkt. De verantwoordelijkheid ligt bij de
voedselverwerkende industrie, díe moet weten of alle onderdelen veilig zijn.”
Naar aanleiding van de fipronil-crisis werd het thema voedselveiligheid binnen de NVWA nadrukkelijker gepositioneerd. Met de aan stelling van een Chief Food Safety Officer (CFSO, sinds kort bekleed door Bernadette Ossendorp) kwam er binnen de NVWA een centrale functie voor voedselveiligheid. Er moest meer focus komen op voedselveiligheid en een betere samenwerking komen tussen de verschillende disciplines. Wat is er intern sinds het aanstellen van de CFSO veranderd?
Graven: “We zijn veel meer onderling gaan sa menwerken! De samenwerking tussen Coen van der Weijden en mij is daar slechts één voor beeld van, maar het gebeurt over de hele linie. We zitten geregeld bij elkaar om elkaar op de hoogte te houden van recente ontwikkelingen.”
Van der Weijden: “De NVWA is opgedeeld in domeinen die tot enkele jaren terug inderdaad redelijk op zichzelf opereerden. We laten nu veel meer pro-actief óver die domeinen heen onderwerpen op elkaar aansluiten. De opleiding voor nieuwe inspecteurs met betrekking tot schoonmaak en hygiëne is daar een mooi voor beeld van. Ook de plaagdierenbestrijding (pest control), een essentieel aspect van hygiëne en voedselveiligheid, is een belangrijk onderdeel. Graven: “Daarnaast starten we binnenkort met een opfriscursus voor inspecteurs in het be oordelen van voedselcontactmaterialen. Doel is dat ze worden gevoed met kennis vanuit alle, voor hun werk relevante, domeinen.”
Wat is het mooie van jullie werk? Waar ben je trots op?
Van der Weijden: “Wij zijn toetser van de wet; er zijn duidelijke grenzen aan wat wij mogen en kunnen doen. Doel van de NVWA-inspecties is naleving verbeteren. Consumenten moeten erop kunnen vertrouwen dat het voedsel dat ze kopen en eten veilig is. Levensmiddelen fabrikanten zijn zélf verantwoordelijk dat ze veilig voedsel produceren; de meesten pak ken die verantwoordelijkheid goed op. We zijn geen adviserende instantie, maar mogen wel ‘naleefhulp’ bieden. Dat doen we bijvoorbeeld door het inzichtelijk maken van de hiaten die we signaleren. We mogen geen advies geven, maar kunnen wel laten zien wát er fout is. En we kunnen aangeven waar men informatie kan vinden om die fouten te verhelpen.”
“Ik vind het geweldig om ondernemers te zien groeien”, zegt Graven. Hij opent een map met foto’s die laten zien hoe een ruimte transfor meerde van een eenvoudige garagewerkplaats naar een brandschone hightech productie locatie. “Deze ondernemer realiseerde in een paar jaar tijd enorme verbeteringen, mede dankzij zogenaamde ‘feedbackloops’. Wij in specteren, geven de hiaten aan, waarop een cyclus ontstaat van continue verbetering. De drang naar verbetering is er en goede kwali teitsmanagers pakken dit uit zichzelf op: niet vanuit een verplichting vanuit de wetgeving, maar omdat ze het zelf willen.”
En daar moeten we met zijn allen naartoe!

















Vóór het gebruik moet een machine in de voedingsmiddelenindustrie uiteraard schoon zijn. Schoonmaken is daarom onderdeel van de algemene beheersmaatregelen binnen het HACCP-plan. Toch gaat het af en toe mis. Daar zijn diverse oorzaken voor aan te wijzen. Eén van de belangrijkste - en vaak ondergeschoven - oorzaak is: verkeerd ontwerp gecombineerd met een gebrek aan een serieuze validatie.
‘Het grote probleem is dat micro-organismen niet met het blote oog zichtbaar zijn. Tegen de tijd dat je ze ziet, ben je te laat’.
Open apparatuur, zoals transportbanden, zijn grotendeels gemakkelijk te controleren op zichtbare verontreiniging. Een transportband lijkt eenvoudig te reinigen, maar is het niet. Vooral niet als er rollen onder de band zijn, die de band ondersteunen. Als de band aan de bovenzijde schoongespoten wordt, dan maakt de nog vieze rol aan de onderzijde de band weer vies. Ook zichtbaar schoon kan zo’n rol de band een microbiële nabesmetting geven. Burggraaf & Partners hanteert hiervoor de begrippen direct en indirect product contactoppervlak. De bovenzijde van de band komt rechtstreeks (direct) in contact met het product en de rol eronder indirect. Beide moeten schoon zijn en zo nodig gedesinfecteerd om veilig te kunnen opstarten.
Lastiger wordt het als het gesloten apparatuur betreft, zoals pompen, afsluiters en meetinstrumenten in een leiding. Alleen bij demon tage is visuele inspectie mogelijk. In de praktijk wordt zo’n proces automatisch gereinigd (clea ning-in-place, CIP). Automatisch reinigen heeft als voordeel dat het reinigingsproces te valide ren is en later te verifiëren. De European Hygie nic Engineering & Design Group (EHEDG) heeft een testmethode ontwikkeld waarbij zulke componenten gevalideerd worden op de reinig baarheid tot op microbieel niveau. De worstcase situatie is een substantiële vervuiling met een test micro-organisme. Daarbij wordt de gehele component na reiniging gevuld met een groeimedium om te controleren of en hoeveel micro-organismen zijn achtergebleven, verge leken met een referentiebuis. EHEDG zegt dan dat als een goedgekeurde component visueel schoon is, er ook van uitgegaan kan worden dat de component tot op microbieel niveau schoon
is. Met andere woorden, het is van belang dat de fabriek later voor de component een worst-case scenario bedenkt, zoals een sub stantiële vervuiling met het te produceren pro duct. Als er daarbij na reiniging nog productres ten achtergebleven zijn, kan de CIP-methode onvoldoende zijn, maar is mogelijk ook het ontwerp niet geschikt voor de toepassing met dit specifieke product. Dit komt soms voor bij producten met een bepaalde visco-elastische eigenschappen.
Naar aanleiding van de resultaten van de testmethode van EHEDG zijn een aantal ontwerpcriteria opgesteld. Die zijn uiteraard terug te vinden in de 52 EHEDG-richtlijnen (www.ehedg.org), maar ook samengevat in de EU-norm NEN-EN 1672-2 Machines voor voedselbereiding - Algemene basisregels - Deel 2: Hygiëne-eisen (www.nen.nl). De richtlijnen en de normen vragen wel om uitleg, en die >>
door Ir. W.N.A. Burggraaf, Burggraaf & Partners B.V.




































































De vraag naar duurzamer geproduceerde voedingsmiddelen stijgt, consumenten kiezen vaker voor plantaardige alternatieven en de voedingsindustrie stapt hier gretig op in. De productie ervan brengt echter andere vormen van vervuiling met zich mee. Om apparatuur, transportbanden en de omgeving optimaal schoon te krijgen, zijn vaak nieuwe reinigingsmiddelen en -technieken noodzakelijk.
“Wij worden regelmatig benaderd door onderne mers die bij de opstart van de productie met hun nieuwe plantbased foodconcept tegen hygiëne problemen aanlopen. Met name de plantaardige oliën in vleesvervangers veroorzaken een lastig
te verwijderen vervuiling.” Aan het woord is Gert Visscher, directeur/eigenaar van Eco2Clean.
Hij vervolgt: “Deze oliën bevatten vaak lange koolstofketens. Hoe langer de ketens, des te moeilijker de olie te verwijderen is.” Eco2Clean
ontwikkelde voor deze nieuwe vervuilingspro blematiek een speciale powerschuimreiniger, PSR A2. Het middel verwijdert zeer effectief de specifieke vette vervuiling die na de productie van vleesvervangers achterblijft.
 door Anna Bruggink - van der Steen
door Anna Bruggink - van der Steen
Met name start-ups zijn ook niet altijd bekend met de geldende hygiëne-eisen in de voedings industrie, merkt Gert in de praktijk. Ter illustra tie geeft hij een voorbeeld van een jong bedrijf dat bevroren grondstof op eiwitbasis gebruikt voor het maken van hun vleesvervangers. “De bevroren grondstof in korrelvorm werd via een transportsysteem een installatie ingeblazen. Bij stilstand ontdooide achtergebleven grond stof in de installatie. Dat hadden ze zich niet gerealiseerd. De installatie was niet in het reinigingsproces meegenomen, en er ontstond een besmetting in het transportsysteem. Na dat we de oorzaak hadden gevonden, bleek de installatie ook nog eens moeilijk te reinigen.” Hij vertelt al meerdere van dit soort voorbeel den in de praktijk te zijn tegengekomen. “Er wordt – begrijpelijk - gefocust op het nieuwe concept en onvoldoende nagedacht over hóe de apparatuur, systemen en machines te reini gen. Het doorvoeren van allerlei aanpassingen achteraf brengt doorgaans flinke kosten met
zich mee. Met een goed doordacht hygiënisch ontwerp kun je dat voorkomen.” Nog een voorbeeld. “Een bedrijf dat insecten kweekt voor de diervoerderindustrie had hygiëneproblemen in de opslagruimte voor grondstoffen. Als voedingsbodem voor het kweken van insecten maken ze gebruik van kwalitatief hoogwaardige organische rest stromen uit de voedingsindustrie. Een duur zaam alternatief, want daardoor zijn ze niet meer afhankelijk van niet-duurzame soja uit bijvoorbeeld Zuid-Amerika. De ondernemers waren echter niet bekend met het feit dat aan het transport en de opslag van reststromen dezelfde hygiëne-eisen worden gesteld als aan de rest van het productieproces. Omdat het om reststromen gaat, is men geneigd daar minder bij stil te staan. Transportmiddelen, opslagsilo’s en apparatuur voor het mengen en doseren moeten op eenzelfde, hoogwaardig niveau schoongemaakt worden. Enorm be langrijk, want wanneer er infecties of andere problemen ontstaan als gevolg van bederf in
het voorproces, heeft dit grote impact op het vervolgproces.”
“Ruim 15 jaar geleden begonnen we met de ontwikkeling van ecologische alternatieven voor ons traditionele pakket reinigingsmidde len”, blikt Gert terug. “Daar zijn we nooit mee gestopt. We steken veel tijd en energie in de ontwikkeling van duurzame alternatieven met weinig of geen milieu-impact. Zo zijn de ten sides en kalkbinders bij een groot deel van de ecologische reinigings- en desinfectiemiddelen inmiddels vervangen door alternatieve, plant aardige grondstoffen. Het middel EcoFoam 6 komt voort uit de reststromen van de kaas- en kwarkproductie van de zuivelindustrie. Deze krachtige, 100% natuurlijke schuimreiniger heeft een uitstekend eiwit- en vetverwijderend vermogen en voorkomt afzettingen van kalk. Omdat het geen gevaarlijke stoffen bevat, zijn persoonlijke beschermingsmiddelen niet nodig. Het kan zonder verdere eisen overal worden opgeslagen, heeft geen invloed op het afvalwa ter en is daardoor veilig voor het milieu. Steeds meer bedrijven in de vleesverwerkende indus trie die duurzaamheid als speerpunt hebben, stappen erop over.”

Een desinfectiemiddel dat zowel quathouden de als ethanolhoudende desinfectiemiddelen kan vervangen is ‘Laquick’. Dit bestaat uit melkzuur en waterstofperoxide, en vervalt na een langdurige werking in water, zuurstof en kooldioxide. “Een extra voordeel is dat er niet nagespoeld hoeft te worden,” zegt Gert. “Dat bespaart dus water én schoonmaaktijd.” En de ontwikkelingen gaan door: “We gebruiken ook nieuwe, duurzame technieken op basis van enzymreiniging en onderzoeken nu in hoeverre de watertemperatuur bij reiniging met specifie ke enzymreinigers kan worden verlaagd. Voor bedrijven met een hoog waterverbruik kan dit, zeker met de huidige energieprijzen, een flinke besparing opleveren!”
‘Hoe langer de koolstofketens, des te moeilijker de olie te verwijderen is’





















Reinigen en desinfecteren gaat over risicobeheersing: het borgen van de hygiëne draagt bij aan het veilig in de markt zetten van jouw voedingsproducten; zodat je je geen zorgen hoeft te maken om recalls. Om dit te borgen heb je procedures ingericht en regels opgesteld, werk je met een hygiënecode en protocollen: ‘ga áltijd door de hygiënesluis, was je handen, gebruik foodgrade smeermiddelen, train het personeel’. Het werkt. Samen hebben we zo een hoge voedselveiligheidsstandaard bereikt.
Maar in de dagelijkse praktijk verslapt de aandacht wel eens. Je hebt je checklist afgewerkt, alle vinkjes gezet en denkt misschien ‘die protocollen kosten zoveel tijd, ik kan wel een keer wat minder doen. M’n de SAP-jes zijn immers al maanden negatief.’ Je wordt wat laks. En dan opeens… is het mis. Je hebt een virus, schimmel of bacterie in je bedrijf.
Het doet me denken aan een tekst uit het boek Prediker; een verhaal over twee houthakkers. De één werkt stug door, zonder pauzes. De ander neemt na iedere omgehakte boom een korte pauze. Aan het einde van de dag constateert de eerste dat de ander, die schijnbaar zoveel tijd verkwistte, veel meer bomen geveld heeft dan hij. Hoe kán dat? Wat blijkt: hij gebruikte de pauzes steevast om zijn bijl te slijpen. Het hakken kostte hem daarna minder kracht en ging sneller. Door de rust bleef niet alleen zijn bijl scherp, de houthakker zelf ook. De moraal: wie wijs te werk gaat, werkt veel efficiënter.
Als het om het borgen van de hygiëne gaat, moet er in je bedrijf een status zijn van voortdurende alertheid en wijsheid. Neem dus de tijd om je mensen te trainen en je systeem continu kritisch te beoordelen. Evalueer jaarlijks je procedures. Maar pas op: bedrijfsblindheid ligt op de loer, dus zorg dat je ook ánderen naar je systeem laat kijken. En dan niet steeds dezelfde ‘andere’, want ook zij werken weer volgens vaste stramien.
Zo houdt je je systeem levend. En blijf jij scherp.
 Directeur Nutrilab
door Pieter Vos
Directeur Nutrilab
door Pieter Vos
Als je jouw klanten al 20 jaar belooft dat je de lekkerste broodjes smeert, dan heb je groot vertrouwen in de veiligheid en de hygiëne van het productieproces. Toch is er altijd ruimte voor verbetering door kennismaking met nieuwe technologieën. Qizini ontdekte de kracht van Simpeldesinfecteren.


Qizini maakt lekkere broodjes. Deze ‘friendly food company’ is gespecialiseerd in belegde broodjes, wraps, sandwiches en panini’s; pro ducten die het bedrijf produceert in haar fabrie ken in Losser en Alphen aan den Rijn. In Losser zijn dat lekkerheden voor de retail, de fabriek in Alphen aan den Rijn richt zich vooral op de luchtvaart. Hier rollen bijvoorbeeld de boxen voor de businessclass van de bekendste Neder landse vliegtuigmaatschappij van de band.
Goede hygiëne is een must in een foodbedrijf als Qizini. De kwaliteit van de voedingsproducten mag onder geen beding in gevaar komen. “Als de
hygiëne niet onder controle is, kan er ellende en imagoschade ontstaan. Dat wil je te allen tijde voorkomen,” benadrukt Walther de Haan, die als operational manager de fabriek in Alphen aan den Rijn aanstuurt. De schoonmaak was in de fabriek op orde, maar toen Walther bij een bezoek aan de fabriek in Losser hoorde over een nieuwe aanpak van desinfecteren, luisterde hij geïnteresseerd mee. Ondanks dat er in Losser ook goed werd schoongemaakt, waren er toch wat moeilijk bereikbare plekjes, zoals in de highcare verpakkingsmachine, die met de be staande ‘natte’ desinfectiemethode niet 100% werden geraakt. Walther vertelt verder: “Op een zondag voerde het bedrijf Simpeldesinfecteren een test met hun Nocotech-systeem uit. Eerst namen de bacteriële waardes toe, omdat de door de jaren heen opgebouwde biofilm werd afgebroken. Daarna begon de afname tot bijna nul. Met als conclusie: een betere desinfectie dan voorheen. Dit wilde ik ook voor de fabriek in Alphen.”
“De kracht van ons systeem is inderdaad volledige desinfectie en het hiermee voorkomen van nieuwe bacterie-aangroei”, vertelt >>
door Esther van der Lelie | foto’s ©Roel Dijkstra

Hugo ter Hoeve van Simpeldesinfecteren. Een ander voordeel dat Hugo benoemt is de efficien cy. “Het aantal schoonmaakuren vermindert tot wel 40%. Voor een optimale werking is het be langrijk eerst de ruimte te beoordelen op inhoud (m³), afzuiging en locatie waar de machine komt te staan of te hangen. Als dit klopt, druk je op de knop of start automatisch het desinfectieproces waarbij een vloeistof op basis van waterstof peroxide verandert in een droge damp. Deze damp bestaat uit ‘superoxides’ waardoor alle micro-organismen geëlimineerd worden; ook op plekken waar mensen niet bij kunnen, zoals in en onder je machines of in de verdampers. Er blijft geen residu achter, er hoeft niet te worden nagespoeld, er komt geen mens meer aan te pas. De Nocotech-methode is 99,9% biologisch en richt geen schade aan bij mensen, dieren en het milieu.”
Hugo ter Hoeve en Robert Kostrubiec zijn samen voor het Nocotech desinfectie principe gevallen.

Deze methode werd volop toegepast in zieken huizen en beiden waren nieuwsgierig naar de werking voor de voedingsindustrie. Het leek ‘too good to be true’, maar dat was het niet! Een samenwerking in de vorm van ‘Simpeldesinfecteren’ was geboren. Robert: “We begonnen bij grote bedrijven met businesscases. Al snel mochten we bij meerdere klanten aan de slag.” Het succes ligt in het geautoma tiseerd desinfecteren én zoals Hugo aanvult: “Onze persoonlijke motivatie om klanten met problemen te kunnen helpen. Je weet dat het echt werkt.”

Simpeldesinfecteren heeft drie types machines, geschikt voor ruimtes tot 20.000 m³. Robert: “Elke klant en iedere setting is anders. We be oordelen de ruimte en bouwkundige staat en bepalen dan welke machine het beste past. Zo kozen we, na een positieve ROI, in Alphen voor een Nocospray en een Nocomax waarmee ze in plaats van wekelijks nu dagelijks desinfecte
ren.” Hugo vult aan: “Bij de start hebben we de medewerkers geïnstrueerd. Het systeem werkt simpel, dus eenmaal uitleg is voldoende.” Walther overziet het totaal met een glimlach: “Ik vind het leuk om met innovatie bezig te zijn, zoals we dat ook doen bij Qizini om steeds meer lekkere broodjes te maken. In dit geval ging het om het verbeteren van de hygiëne.” Hij kan met een gerust hart aantonen dat de fabriek volledig schoon is en hiermee voldoet aan de aan Qizini toegekende en vereiste IFS-certificering. Hij is blij met de samenwerking met Simpeldesinfec teren. “Samen speel je het spel van techniek, planning en overleg.” Uiteindelijk wordt er een sterk staaltje desinfecteren geleverd. “En daar doen we het voor”, besluiten Hugo en Robert.
www.simpeldesinfecteren.nl www.qizini.com
Zuneha levert vers vlees aan de slagerijbranche. Onlangs investeerde het middelgrote bedrijf in een nieuwe CO2 koelinstallatie met warmteterugwinning. De warmte van de koelingen wordt gebruikt om het water te verwarmen; daarmee kan fors worden bespaard op het gasverbruik.

Zuneha is van oorsprong een familiebedrijf. Het bedrijf, opgericht in 1960, was aanvankelijk grossier en leverde droge kruidenierswaren aan winkels in de omgeving. De vleesverwerking kwam er gaandeweg bij en is nu de core busi ness van het bedrijf. In 2000 verhuisde Zuneha van Halsteren naar Tholen. Aan het roer staan directeuren René Visser en René van Dijke. “Ik had altijd de ambitie om mijn eigen zaak te v.l.n.r. René Visser, Guustaaf Hoekstra en René van Dijke
hebben,” vertelt Visser. Hij werkt inmiddels al 34 jaar voor het bedrijf en kon het overnemen van de familie Moerland. “Ik ga nog altijd met ple zier naar het werk.” Net als alle medewerkers van Zuneha draait hij volop mee in het bedrijf. “Onze medewerkers springen overal bij. Nie mand heeft een vaste werkomschrijving, men helpt waar nodig. Alleen het uitbenen wordt door onze specialisten gedaan.”
Zuneha levert vers vlees - rund, kip, kalkoen en varken - aan slagerijen. Daarnaast handelt het bedrijf in kant-en-klare sauzen en salades. De bestellingen worden dagelijks dagvers geleverd. “Ik geloof niet zo in diepvriesvlees,” zegt Visser. “Wij kiezen voor vers. Kwaliteit en betaalbaar heid staan voorop en ook dierenwelzijn vinden we belangrijk. Ons varkensvlees komt van Duroc d’Olives varkens, een Belgisch varkens ras. In België hanteren ze geen sterrensysteem zoals in Nederland, maar vertaalt naar ons systeem kun je spreken over varkens vlees met twee sterren.” Ook duurzaamheid is belangrijk voor Zuneha. Het bedrijf doet wat mogelijk is; voor het milieu én om kosten te besparen. Anderhalf jaar geleden investeer den ze daarom in nieuwe koelingen, en in een warmteterugwinsysteem dat werd geleverd door LETS bv. “De warmte wordt gebruikt om het water te verwarmen voor de reiniging en het handenwassen.” LETS is een vaste partij voor Zuneha, ook andere installaties werden via hen aangeschaft. “We doen al ruim twintig jaar zaken samen. Ze hebben ook een persluchtinstallatie, hogedrukreiniger en waterontharder geleverd,” aldus Visser.
“Onze koelingen waren verouderd,” vervolgt hij. “Ze waren nog niet afgeschreven hoor, maar vanuit milieuoverwegingen kozen we toch voor een nieuwe koelinstallatie. Het kostenplaatje speelde ook mee: chemische koudemiddelen, nodig voor die oude koelingen, zijn steeds lasti ger te verkrijgen en daarmee kostbaar.”
Guustaaf Hoekstra, directeur van LETS, legt uit wat de voordelen zijn van een dergelijke instal latie: “CO2 als koudemiddel is niet schadelijk voor het milieu, en niet brandbaar, giftig of explosief. Er is aanzienlijk minder energie nodig om CO2 te produceren dan chemische koudemiddelen. CO2 koelinstallaties zijn behalve energiezuiniger ook kostenbesparend op langere termijn. Dankzij de hoge temperaturen aan de hoge druk zijde van de CO2 compressiecyclus, kan warmte worden teruggewonnen. Daarmee is deze koeling een ecologisch, energetisch en economisch verantwoorde oplossing. Een warmteterugwininstallatie kan erg interessant zijn voor bedrijven, vooral wanneer het bedrijf gebruik maakt van warm water,” aldus Hoekstra.
“Zeker met de gasprijzen van vandaag de dag, is het een interessante investering.”
“De terugverdientijd van een warmteterugwininstallatie is met de huidige prijzen teruggelo pen naar 1 tot 3 jaar. Voorheen was dat 5 tot 7 jaar. Niet alle koelingen zijn echter geschikt voor warmteterugwinning. Het is daarom belangrijk om je hierover goed te laten adviseren.” zegt Hoekstra.
Om te bepalen wat een bedrijf nodig heeft qua installatie en wateropslag, en een goed advies te kunnen geven, voert LETS in het voortraject altijd een uitgebreid gesprek met de klant. “Wel ke capaciteit heeft men nodig aan verwarming? Moet er worden bij-verwarmd? Dit om over- of ondercapaciteit te voorkomen. Het is zonde om te kiezen voor een zwaardere installatie en grotere watertank dan nodig is.”
Eén van de voorwaarden voor Zuneha bij het ver vangen van de koelingen en het installeren van de warmteterugwininstallatie was dat het be
drijf gewoon kon doordraaien. “Daarom hebben we tijdelijk een koelcontainer laten plaatsen.” De CO2 installatie en het reservoir staan buiten het bedrijf, in containers die met elkaar gescha keld zijn. “Binnen hadden we geen plek voor de installatie, dus dit is een prima oplossing. We hebben een opslag met ruimte voor achtduizend liter water, dat constant op temperatuur wordt gehouden. Hiermee hebben we genoeg capaciteit voor de schoonmaakwerkzaamheden. Mocht er onverhoopt een storing zijn in het systeem, dan kunnen we alsnog terugvallen op het oude systeem en het water verwarmen middels een gasaansluiting. Tot dusver heb ben we dat niet nodig gehad. Het draait als een zonnetje.” Hoekstra: “De nieuwe koelingen met warmteterugwininstallatie bieden hier echt een meerwaarde voor het bedrijf. Deze investering betaalt zich binnen afzienbare tijd terug.”
www.letsbv.nl www.zuneha.nl

Dagelijks met 70 man foodbedrijven schoonmaken, iedere week 500.000 kratten en 12.000 stuks bedrijfskleding wassen, met een smile extra taken van jouw klanten overnemen, je business blijven optimaliseren en ambitie hebben. Dat vereist pure dedication, een goed team en fijne partners.
Ondernemerspaar Patrick Vendrig en Gosia Wrobel draaien er hun handen niet voor om. Van jongs af aan zijn ze gewend hard te werken. Eerst bij de poelier, waar ze elkaar leerden ken nen. Later als schoonmaakondernemers. Toen de poelier met zijn bedrijf stopte, raadde hij Patrick aan om zich als schoonmaakbedrijf bij de Kamer van Koophandel in te schrijven: ‘Bij een poelier werken betekent veel schoonma ken, dat kun je en zo behoud je werk’. Hun in eerste instantie afwachtende houding, ‘we kij
ken even hoe dit loopt’, duurde niet lang. Binnen twee maanden waren er 11 schoonmaakklan ten in de voor hun zo bekende vleesverwerken de industrie.
Door de jaren heen is PG Cleaning uitgegroeid tot een totaalleverancier met 70 medewerkers, gespecialiseerd in reiniging en desinfectie bij de vleesverwerkende industrie, portiersdiensten, levering van schoonmaakmaterialen en disposables. Door hun toegewijde inzet bij klanten kregen Patrick, Gosia en hun medewer kers vragen voor extra werk: krattenwassen en
later ook het wassen van bedrijfskleding. Een uitdaging voor reguliere wasserijen vanwege de vlees- en kruidenvlekken. Zusterbedrijf PoulServices werd opgericht. Patrick vertelt trots: “We reinigen nu iedere week zo’n 500.000 kratten en 12.000 stuks kleding.”

“Wat rekenen jullie voor het wassen van kle ding?” Met die vraag van één van de klanten van PG Cleaning begon het avontuur van kle dingwassen voor de schoonmaakondernemers. Een mooie aanvulling die zij graag goed wilden invullen. Daarom zochten zij een partij die met hen kon meedenken over de specialistische reiniging die bedrijfskleding van vleesverwer kers nodig heeft. Dit werd Christeyns. Er startte een nauwe samenwerking, waarbij verschillen de soorten moeilijke vlekken kritisch werden beoordeeld en de wasprocessen steeds verder werden geoptimaliseerd om tot het gewenste resultaat te komen.
“Het wassen gaat bijna 24 uur per dag door, we wisselen iedere dag bij de klanten”, legt Patrick uit. “Met deze hoeveelheid en frequentie moet je goed kijken welke middelen je nodig hebt en hoe je deze gebruikt”, vervolgt Anthony

Hendriks van Christeyns. “Wasmiddelen kun je overal kopen. Het gaat om de juiste begeleiding om te komen tot ‘low impact washing’.”

“Dat betekent dat we met de juiste wasmid delen zorgen voor een minimaal gebruik van water en energie en bovendien de slijtage van
het textiel tot een minimum beperken”, zegt Patrick. “Een samenspel van kennis, ervaring en de juiste chemie, waardoor de kleding veel wasbeurten langer meegaat.”
Anthony: “Vanuit onze afdeling Christeyns Consultancy helpen wij onze relaties onder
andere door hun medewerkers op te leiden. Dat kan vanaf de basis tot en met zeer gevorderd. We leren deelnemers bijvoorbeeld wat belang rijk is bij het wassen van hun specifieke pakket, hoe zij veilig omgaan met de professionele middelen en wat zij moeten doen om ook na het >>




























wasproces te zorgen dat de gewassen kleding hygiënisch schoon blijft. Daarom adviseren we ook al in het voorstadium over de inrichting van de wasserij. Wij snappen wat erbij komt kijken om een schoon en hygiënisch kledingstuk af te leveren. Over de hygiëne in de wasserij van PoulServices zijn geen zorgen. Dankzij de juiste wasprocessen, regelmatige hygiënecontroles én natuurlijk hun eigen schoonmaakkennis is deze optimaal.”

Anthony denkt graag mee over vraagstukken in de wasserij: “We hebben Gosia bijvoorbeeld geholpen met haar vraag hoe de ISO9001-
certificering aan te pakken.” “Binnen een half jaar is het gelukt”, lacht de onderneemster. “Het heeft mij veel tijd en energie gekost, ik ben er trots op.” Er wordt hier echt dedicated gewerkt, hygiëne staat op nummer één en er wordt in de wasserij alleen voor foodbedrijven gewerkt. Volgens Anthony is dat wat PoulServices onder scheidt van andere wasserijen. En die aandacht voor het werk geven Patrick en Gosia ook door aan de volgende generatie. Hun kinderen hel pen al een handje mee.
SAMEN DE TOEKOMST IN
Als partners is het belangrijk om op elkaar te kunnen vertrouwen. Patrick: “We moeten snel
kunnen schakelen, kunnen niet stilstaan. Daar om hebben we korte lijnen met Christeyns.”
“Het is echt samen denken en doen”, vult Gosia aan. “Samen optrekken, ontzorgen, optima liseren, problemen oplossen en van elkaar leren”, laat ook Anthony weten. Met vertrouwen worden de plannen voor de toekomst gedeeld, waarbij het (reinigings)bloed van de schoon maakondernemers kruipt waar het niet gaan kan: “We wassen de kratten nu op drie locaties, en willen er nog een vestiging in regio Oudewater bij. Eigenlijk willen we elk jaar wat nieuws op zetten; inspelen op wat er leeft in de markt.” www.christeyns.com
Freshfel Europe begint samen met haar leden aan de ontwikkeling van een schaduw PEFCR (Product Environmental Footprint Category Rules) voor groenten en fruit. Doel van de schaduw PEFCR is de ontwikkeling van een geavanceerde, gestandaardiseerde milieuvoetafdrukmethode voor de sector verse producten. Zodra de schaduw PEFCR is ontwikkeld, zal de benchmarking en de vergelijking van de milieuvoetafdruk van producten binnen de categorie verse producten worden verbeterd. Dit zal de transparantie, de verantwoordingsplicht en de communicatie over milieukwesties in de sector vergroten, aangezien ‘groenten en fruit’ een van de meest duurzame levensmiddelencategorieën is.




Géén coating, maar door en door antibacterieel én antiviraal; dát is wat Jackit met Sealwise gerecyclede panelen al meer dan twee jaar succesvol monteert bij renovaties voor de voedselverwerkende industrie. De panelen hebben brandcertificering Bs1do, zijn 100% waterdicht, en snel en veilig schoon te maken. “Veiligheid staat bij ons voorop, zowel voor de medewerkers als voedselproducten. Daarom passen wij Sealwise panelen toe,” zegt Jack Pluim van Jackit. Ontdek hoe u ook uw bedrijf veilig en snel kan laten renoveren. Kwaliteit met een verrassend lage TCO.
Het producentenvertrouwen in de voedingsindustrie is recent omgeslagen van overwegend positief naar negatief. Hogere energieprijzen zullen in 2023 verder doorsijpelen in de keten doordat meer en meer oudere gunstige contracten aflopen. Verder liggen veel grondstofprijzen nog steeds op een relatief hoog niveau. Afzetprijzen zijn momenteel ruim 25% hoger dan begin 2020 en de meerderheid van de voedingsproducenten is van plan om verkoopprijzen verder te verhogen. Hoewel de omzet van de sector in 2023 stijgt als gevolg van hogere prijzen, verwacht ING druk op marges en volumes doordat consumenten naar goedkopere producten op zoek gaan.
www.jackit.nl/sealwise






















nium; de stikstofcrisis is slechts het begin. Ze verwacht o.a. problemen met de kwaliteit van het oppervlaktewater, bodemdaling en broeikas gasemissies. “De overheid schuift deze proble men voor zich uit,” Ze spoort daarom de sectoren aan deze issues proactief aan te pakken. “Wacht niet tot de overheid wat doet, want dan loop je van het ene drama in het andere.”
Op 3 november vond het jaarlijkse COV Meat Café plaats in Dauphine Amsterdam. Ruim 50 genodigden uit de agri- en foodsector debatteerden over de ideale eiwitbalans. Wat is een gezond eetpatroon? Welke rol speelt de prijs bij de consument? Kun je vlees en vleesvervangers wel met elkaar vergelijken? Het leverde voer voor discussie en stof tot nadenken.
Voorzitter van de COV Laurens Hoedemaker benoemde tijdens zijn welkomstwoord het belang van een open dialoog als het gaat om de eiwittransitie. Dat past ook bij de nieuwe aanpak van de COV om meer naar buiten te treden: “Als sector worden we voortdurend uitgedaagd. Het is belangrijk om daarbij het verhaal over vlees te blijven vertellen. We moeten durven twijfelen aan de dingen die we doen; klopt het? Maar we moeten óók trots zijn op de producten en processen die onze bedrijven zo goed maken.” Na zijn welkomst woord openden drie gasten het debat met prikkelende columns.
Gerda Feunekes (Voedingscentrum) gaf aan dat er een betere balans moet komen in de con sumptie van dierlijke en plantaardige eiwitten. Daarvoor is een verschuiving in ons eetpatroon nodig: de eiwittransitie. “Nederlanders eten nu gemiddeld 700 gram vlees per week, het Voedingscentrum adviseert 500 gram per week omdat dat beter is voor onze gezondheid en het milieu.” Ze pleitte bovendien voor meer verse en minder bewerkte producten op het bord.
Universitair hoofddocent Sanderine Nonhebel (RUG) waarschuwde de vee- en vleessectoren voor grote uitdagingen in het komende decen
Thea Smit, Vion-directeur productontwikke ling, benadrukte dat veel bedrijven al actief bezig zijn met plantaardige en duurzamere productielijnen. “De consument bepaalt wat wij produceren. Prijs en versheid blijken bepalend voor hun aankoopgedrag. Maar nu ze minder te besteden hebben, wordt prijs steeds belangrij ker. Als een product niet gekocht wordt omdat men het te duur vindt, wat heeft de productie dan voor zin? En is de consument de betutteling niet een beetje moe?” vraagt ze zich hardop af.
Debatleider Gijs Weenink poneerde na deze co lumns zeven stellingen, waarbij de deelnemers steeds opnieuw een standpunt kozen: eens of oneens. Enkele stellingen draaiden om het be wegen van consumenten naar een ander koop gedrag of voedingspatroon; met minder vlees, meer groente, geen kiloknallers meer. ‘Keuze vrijheid’ vindt men een groot goed, maar om een goede keuze te kunnen maken, is er wel eerlijke informatie nodig. ‘Wat vergelijk je met wat? De milieu-impact van een kilo boontjes met een kilo vlees? Neem je daarin ook de nutriënten en hoeveelheid eiwit van die kilo’s mee?’ Uit de vragen en opmerkingen van de deelnemers blijkt wel weer hoe ingewikkeld het debat is en hoeveel ruimte er moet zijn voor nuance.
Na afloop bij de borrel, werd er uitgebreid na gepraat en van gedachten gewisseld; ook nu weer in een open sfeer waarin écht naar elkaar werd geluisterd.
Bacteriën zijn overal maar vaak ongewenst. Zeker in omgevingen als laboratoria en voedingsbedrijven mogen deze geen kans krijgen. Hoe kun je dan aangroei voorkomen? Met hoogwaardige kwaliteit antibacteriële wanden en hygiënische vloeren als vaste basis.
Vloerenspecialist Ruys Groep en renovatiespe cialist Jackit zorgen samen voor een antibacte riële basis als totaaloplossing voor nieuwbouw en renovaties bij onder meer voedingsbedrijven, laboratoria en grootkeukens. Een intensieve sa menwerking die in 2020 ontstond, nadat beide partijen elkaar al jarenlang op de werkvloer hadden ontmoet. Jack Pluim, directeur Jackit verklaart logisch: “Wij leveren samen kwaliteit en die wint altijd. Hendrik Ruys, directeur Ruys Groep beaamt: “We hebben elkaar gevonden in het compleet ontzorgen van de klant.”

Jack vertelt dat Jackit exclusief partner is van

Sealwise, een oplossing van duurzaam gerecy clede pvc-wandpanelen die 100% waterdicht zijn en volgens wetenschappelijke tests op de toplaag, 99,8% virussen zoals SARS-CoV-2 en MERS-CoV doodt.
Ruys Groep is expert in efficiënte en duurzame vloeren en volgens Jack de grootste in goede af schotvloeren. “Dat moet inderdaad gewoon goed zijn, in de sectoren waar wij werken mag geen water blijven liggen”, verklaart Hendrik. “Om te bepalen welke vloer het beste in de ruimte past gaan wij in gesprek met onze klanten en architecten. Zo krijgen we een goed beeld van het (productie)proces en de bijhorende wensen en eisen. In ons plan van aanpak beschrijven wij
de optimale vloer per ruimte én details zoals de locaties van putten, goten, plinten, stootbanden en naadloze vloerovergangen.”
De opdrachten voor dit team komen via hun net werk binnen. Hendrik: “We hebben jarenlange ervaring, 90% van de bedrijven in de voedings sector kent ons.” Ook Jack mag op zijn kennis en kunde vertrouwen: “Klanten van ruim 30 jaar geleden komen terug omdat we meer doen dan gewenst is en problemen oplossen.” Samen bieden ze een totaalpakket dat voldoet aan de normen en eisen per branche.
Via een bekende architect kregen Ruys Groep en Jackit met Sealwise onlangs een mooie, nieuwe opdracht: de renovatie van een kantorengebouw van zes verdiepingen met op iedere verdieping een laboratorium. Bestemd als uitbreiding van het laboratorium bij het UMC/AMC ziekenhuis in Amsterdam. De vraag was om alle vloeren en de binnenwanden van de buitenmuren te plaat sen. Als blijvende hygiënische basis. ‘Vloeren dokter’ Herman Schrage is vanuit Ruys bij deze opdracht betrokken. Met 50 jaar ervaring vertelt hij over de opdracht: “Samen met de architect hebben we gekeken wat voor de renovatie nodig
door Esther van der Lelie | foto’s ©Cor Salverius Fotografieis, en wat de toepassing van de ruimtes is, zodat de juiste vloer op de juiste plek komt. Jack vult aan: “Daarbij komt dat de opdrachtgever alles in één lijn wil. Zo moeten de wanden even hoog komen als de ramen, en de platen in één lijn doorlopen. Dit vereist heel nauwkeurig werken.” De klant koos voor een effen, lichte kleur giet vloer. De vloer is naadloos, dampdicht, vloeistof dicht, chemisch bestendig en makkelijk schoon te maken. Samen met een naadloze holle hoek met plint zorgt dit voor een hygiënisch geheel.
De wanden zijn door en door antibacterieel, gekit met kit van gecertificeerd merk Innotec: “Het enige merk met meerjarige garantie tegen schimmels”, stelt Jack.


“Renoveren doe je maar één keer, dat moet gelijk goed zijn. De tijd die je hiervoor krijgt, verschilt per sector”, vertelt Jack. “Voor de op dracht in Amsterdam hebben we drie weken per verdieping. In de food is dat vaak alleen op de zaterdag en zondag, want de productie gaat daarna weer door.” Herman: “Een ander verschil is dat je in voedingsbedrijven ‘hufterproof’ moet bouwen, want met elektrische karren wordt veel kapotgereden. Ook is daar een antislip vloer belangrijk voor de veiligheid.”
Verder benoemen de heren de verschillen in normen en hygiëne-eisen. Deze zijn in een la
boratorium hoger dan die voor food. Hendrik: “Dus wat voor de eerste sector goed is, is voor de tweede eigenlijk optimaal.” Die vereisten komen wel steeds dichter bij elkaar. Jack: “Keuringen van bijvoorbeeld HACCP, IFS of BCR worden strenger en zonder datum aangekondigd: ‘we komen in november’.” Hendrik vervolgt: “We zorgen er dan ook altijd eerst voor dat de functi onaliteit perfect is, daarna pas hoe mooi. In een bestek staan soms voorwaarden genoemd die hier niet aan voldoen. Dan moet je wat anders durven voor te stellen. Of het niet doen. Dat hebben we door de jaren heen goed geleerd. De klant moet immers tevreden zijn op dag één, maar het ook blijven op dag 5.000 of 10.000.”
www.ruysgroep.nl www.jackit/sealwise.nl

Als medewerker in een levensmiddelenbedrijf weet jij als de beste dat je hygiënisch moet werken. HACCP, reiniging en desinfectie en registraties kennen voor jou geen geheimen. Maar zeg eens eerlijk: gaat onderstaande gedachte echt nooit door je hoofd?

“Ach, zo nauw komt het niet met die schoonmaak. Ik moet de productiecijfers van deze week halen! Eén poetsbeurtje minder zal niemand merken.”
Om de productiecijfers te halen, werk je jezelf het snot voor de ogen (wat dan hopelijk niet in het product valt dat net over de lijn - die je toch al niet zo goed had schoongemaakt- komt). Aan het eind van de dag ga je met een tevreden gevoel naar huis. Je hebt lekker gewerkt, de targets zijn gehaald. Tot je op een dag op het werk komt en iedereen in rep en roer is.
Geschrokken vraag je wat er aan de hand is. Een collega vertelt dat een consument is overleden na het eten van een product dat uit jullie fabriek komt. De NVWA staat op de stoep. Alle producten moeten worden teruggehaald uit de supermarkten. Op het televisiescherm in de kantine komt het nieuwsbericht voorbij; je bedrijf is ineens trending topic, wat in dit geval helaas helemaal geen goed teken is. Het management is in alle staten. Wat als er nog meer consumenten ziek worden of overlijden? Zou het bedrijf dit voedselveiligheidsschandaal nog te boven komen?
Ongemakkelijk achter je oren krabbend vraag je jezelf af of jij dit schandaal had kunnen voorkomen; als jij die dag dat je zo met de targets bezig was, misschien wat beter had gepoetst. Je neemt jezelf voor om de volgende keer (áls die er komt, want jouw bedrijf staat zo ongeveer op instorten) netjes het schoonmaakschema te volgen. Dat kwaliteit voor kwantiteit gaat, heb je nu wel ondervonden. Met een beetje geluk denkt het management hier inmiddels ook zo over.
Normec Foodcare

Vakona is gespecialiseerd in de ontwikkeling en productie van machines voor de voedingsmiddelenindustrie. De focus van deze partner van Sismatec ligt op tumblen, mengen en masseren; zowel met als zonder vacuüm. De Vakona ESK tumblers zijn met name breed inzetbaar in de vlees-, gevogelte- en visverwerking. Deze tumblers hebben een eenvoudige bediening en reiniging en hoge gebruiksvriendelijkheid. De machines kunnen volledig naar wens worden samengesteld door een breed scala aan uitrustingsopties, zodat er een product wordt geleverd dat perfect aansluit op uw wensen en proces. Meer informatie over het Vakona assortiment is op aanvraag verkrijgbaar.


In alle winkels van Albert Heijn kunnen klanten sinds 31 oktober 2022 producten kopen met kortingen oplopend van 25%, 40% tot 70%. Het principe van deze kortingen heet dynamisch afprijzen. Producten die tegen de houdbaarheid aanlopen, worden via dit elektronische systeem met korting aangeboden. Op deze manier blijft er minder over in de schappen, wordt er minder voedsel verspild en kunnen klanten kiezen voor producten met een gereduceerde prijs. Albert Heijn heeft nu in alle winkels met zelfscan en elektronische schapkaartjes het digitale alternatief van de 35%-sticker. De precieze korting wordt automatisch op het elektronische prijskaartje getoond. Bij dynamisch afprijzen berekent een door Albert Heijn ontwikkeld algoritme automatisch de beste korting om aan het einde van de dag geen onverkoopbare producten over te houden.
Nederlanders eten meer vis dan vorig jaar. Gemiddeld aten we in ons land 9,5 kg vis per persoon. In de ranking van alle Europese landen staat Nederland daarmee op de 12e plaats; een redelijk goed gemiddelde, al is dit voor een land dat grenst aan zee met veel verse, eigen aanvoer best opmerkelijk. Dit blijkt uit het onderzoek dat het Nederlands Visbureau jaarlijks laat verzorgen door GfK. Een terugblik op het jaar 2021-2022 leert onder meer dat men gemiddeld ook meer verschillende soorten vis eet, vooral buitenshuis, terwijl de top vijf lijst van meest gegeten vissoorten nog altijd wordt aangevoerd door zalm, tonijn, haring, kabeljauw en mosselen.


Schoonmaken in de voedingsmiddelenindustrie gebeurt niet overal op één en dezelfde manier. Sterker; de meeste bedrijven werken met een compleet eigen en unieke schoonmaakplan. “De rol van de schoonmaker is veranderd: van generalist naar specialist, van louter uitvoerder naar uitvoerder én adviseur met verstand van zaken. Wij werken naar de wensen van de klant”, vertelt Irene Groenen, rayonmanager bij Hago Food & Industry. “Een goed schoonmaakplan opstellen om de voedselveiligheid te borgen is een complex proces waar soms wel drie maanden overheen gaan.” Waarom een uniek schoonmaakplan zo belangrijk is? Irene legt het uit.
www.hagofoodandindustry.nl


Compaxo Groep B.V. en de aandeelhouders van Maasland Vleeswaren B.V. hebben overeenstemming bereikt dat Maasland Vleeswaren B.V. onderdeel wordt van de Compaxo Groep. Met deze overname breidt familiebedrijf Compaxo haar brede portfolio aan vers varkensvlees, vleeswaren en vleesvervangers uit met lever- en kookworsten, hammen en andere (lokale) specialiteiten, aansluitend bij haar one-stop-shop strategie. Jeroen van der Post, directeur van Compaxo Gouda B.V.: “Met Maasland Vleeswaren B.V. breiden we ons productassortiment uit met hoogwaardige private label en eigen merk producten, maar ook met vele jaren aan opgebouwde kennis in het prachtige ambacht.’’ www.compaxo.nl
CIJFERS
& FEITENDe varkensvleesproductie in de Europese Unie zal in 2022 vijf procent lager uitvallen dan in 2021. In 2023 wordt een verdere daling van de productie met 0,7 procent verwacht. Dat staat in de kortetermijnprognose van marktanalisten van de Europese Commissie. De daling is met 10 procent het grootste in Duitsland. Ook in België en Polen zijn de procentuele dalingen met respectievelijk zo’n 9 procent en ruim 8 procent groot. Ook in Italië is procentueel een stevige daling zichtbaar: bijna 3 procent. In Nederland komt de daling in productie naar verwachting uit op zo’n 1 procent. Spanje is het enige land waar volgens de Europese analisten dit jaar een stijging in productie zichtbaar gaat zijn. Die blijft wel beperkt tot 1,6 procent, terwijl dat in 2021 nog een plus van 3,7 procent was.
www.varkens.nl






















































De huidige chemische en thermische processen die worden gebruikt om de hygiëne en veiligheid van producten te borgen, kennen nadelen. Koud plasma kan een mild alternatief zijn bij de bestrijding van micro-organismen, microbiële sporen en virussen. Wat houdt deze technologie in en wat kan de voedingsindustrie ermee?

De laatste jaren verschijnen er veel weten schappelijke publicaties van studies naar de toepassingen van niet-thermische plasma technologie (koud plasma) in de voedings middelenindustrie. Onderzoekers hebben namelijk ontdekt dat plasma’s opererend bij atmosferische condities een inactiverende werking hebben op een breed scala aan micro-organismen; waaronder ziekte- en bederfveroorzakende bacteriën en schim mels, maar ook microbiële sporen en virus sen. Deze werking vindt bij een relatief lage gastemperatuur plaats. Er zijn standaard bedrijfsgassen (perslucht, zuurstof, stikstof), water en energie voor nodig, en op het product vinden geen thermische degradatie-effecten plaats. Bovendien is het een droog en residu-
vrij proces. Ondanks deze voordelen wordt plasmatechnologie in de voedingsmiddelenin dustrie nog niet toegepast. Waarom niet?
Deels komt dat door een gebrek aan appara tuur die op relevante schaal en op flexibele wijze op voedingstoepassingen kan opereren. Bovendien is er nog te weinig kennis over (1) de relatie tussen chemische samenstelling en de effectiviteit op het micro-organisme; en (2) de effecten van plasma-behandeling op de kwaliteit, nutritionele parameters en veilig heid van voedselproducten. Verder is het toe passen van plasmatechnologie op voedings middelen nog niet wettelijk toegestaan. Een voorwaarde voor toelating is dat de veiligheid >>
voldoende onderbouwd is voor de beoogde toepassing. Daarom werken veel onderzoeks groepen aan plasmatechnologie waarmee gedetailleerde kennis wordt opgebouwd die nodig is voor de opbouw van een dossier; en daarmee tot de toekomstige implementatie in de voedingsmiddelenindustrie. Een van deze onderzoeksprojecten is het Nederlandse Plasma4Hygiene project, dat begin 2023 afloopt.

Het Plasma4Hygiene project is een multidis ciplinaire samenwerking tussen onderzoekers van TU/e-EES (met kennis van elektrische systemen en plasmachemie) en onderzoekers van Wageningen Food & Biobased Research (met kennis aan de product- en proceskant en voedselmicrobiologie). In het consortium nemen daarnaast bedrijven deel uit zowel de hightech- als levensmiddelensector. Het project is gefinancierd vanuit de Topsectoren AgriFood (projectcode AF17202) and HighTech systems en de bedrijven in het consortium. Binnen het project zijn een aantal plasmaproductcombinaties onder de loep genomen. Doel van het onderzoek is meer duidelijk heid te verkrijgen over de mogelijkheden en beperkingen van deze technologie voor de voedingsmiddelensector.
Bij de TU/e is binnen dit project een nietthermische, laag vermogen plasma-jet ontwikkeld die een atmosferisch luchtplasma genereert. Met deze plasmabron zijn experimenten op producten bij Wageningen Food & Biobased Research uitgevoerd. Daar naast is in Eindhoven gewerkt aan de ontwik keling/verbetering van emissie spectroscopie als plasma diagnostiek. Hiermee kan de samenstelling, en dus ook de activiteit van het plasma, in kaart worden gebracht. Dit is belangrijk voor het monitoren, controleren en sturen van plasmaprocessen in toekomstige toepassingen op industriële schaal.
Koude plasmatechnologie wordt nu hoofd zakelijk gebruikt in de halfgeleiderindustrie voor de productie van ‘wafers’. Daarnaast is er een sterke ontwikkeling om de technolo gie in te zetten voor de reiniging van rookgas en afbreken van vluchtige organische componenten en stank; voor oppervlakte modificatie van kunststoffen en non-woven materialen; en voor in biomedische applica ties (ontsmetten en genezen van wonden, tandzorg en behandeling van kanker).
We kennen in het dagelijks leven drie verschij ningsvormen van materie: vast, vloeibaar en gas. Maar er is nog een vierde toestand: plasma. Het bestaat uit een mix van fotonen, neutrale, reactieve en geladen deeltjes die een collectief gedrag vertonen. Plasma is eigenlijk elektrisch geladen (geïoniseerd) gas. De overgang van een gas naar een plasma vindt geleidelijk plaats, met toenemende thermische energie.
Een plasma ontstaat door inkoppeling van elektrische energie in een gas via energeti sche elektronen. Door effectieve botsingen krijgen de gasdeeltjes (atomen en moleculen) tijdelijk een hoger energieniveau en verlie zen ook electronen, waarbij een zeer reactief gasvormig medium ontstaat, bestaande uit energetische moleculen en atomen, radicalen, ionen en UV straling. Atmosferische plasma’s in lucht produceren naast reactief zuurstof (bv. hydroxylradicalen en ozon) ook reactief stikstof (stikstofoxides, stikstofoxyzuren), die onder meer tot inactivering van pathogene micro-organismen, dus desinfectie, leiden. Bombardementen van energetische ionen (electroporatie) en inwerking van UV fotonen dragen hier ook aan bij.
Bij koude plasmatechnologie blijft de tempe ratuur van de zware gasdeeltjes (de neutrale deeltjes en ionen) heel laag, waardoor er op energetisch efficiënte wijze reactieve deeltjes kunnen worden geproduceerd. De tempera tuur van het behandelde oppervlakte blijft daarbij laag. Hoewel in het wetenschappelijke onderzoek een breed scala aan gassen wordt gebruikt om plasma te genereren, zijn voor























































































